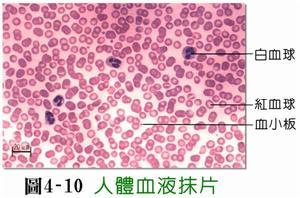
人体血液抹片

-
血液 编辑
血液是流动在人的血管和心脏中的一种红色不透明的黏稠液体。血液由血浆和血细胞组成,一升血浆中含有900—910克的水,65—85克的蛋白质和20克的低分子物质,低分子物质中有多种电解质和有机化合物,血细胞包括红细胞和白细胞和血小板三类细胞。红细胞平均寿命为120天,白细胞寿命为9—13天,血小板寿命为8—9天。一般情况下,每人每天都有40ml的血细胞衰老死亡。同时,也有相应数量的细胞新生。血液的功能包含血细胞功能和血浆功能两部分,有运输、调节人体温度、防御、调节人体渗透压和酸碱平衡五个功能。
主要成分为血浆、血细胞、遗传物质(染色体和基因)。 是一种特殊的结缔组织, 即生命系统中的组织层次。血液中含有各种营养成分,如无机盐、氧以及细胞代谢产物、激素、酶和抗体等,有营养组织、调节器官活动和防御有害物质的作用。血液储存着人体健康信息,很多疾病需要验血。包括遗传病。
中文名:血液
外文名:blood
成分:血浆和血细胞
类别:结缔组织
血液是在心脏和血管腔内循环流动的一种组织。成人的血液约占体重的十三分之一,相对密度为1.050~1.060,pH值为7.3~7.4,渗透压为313毫米每升。由血浆和血细胞组成。血浆内含血浆蛋白(白蛋白、球蛋白、纤维蛋白原)、脂蛋白等各种营养成分以及无机盐、氧、激素、酶、抗体和细胞代谢产物等。血细胞有红细胞、白细胞和血小板。机体的生理变化和病理变化往往引起血液成分的改变,所以血液成分的检测有重要的临床意义。ABO血型是人类的主要血型分类,可分为A型、B型、AB型及O型。
血液的功能包含血细胞功能和血浆功能两部分,有运输、调节人体温度、防御、调节人体渗透压和酸碱 平衡四个功能。红细胞主要功能是运进氧气运出二氧化碳,白细胞的主要功能是杀灭细菌,抵御炎症,参与 体内免疫发生过程,血小板主要在体内发挥止血功能,血浆功能主要为营养,运输脂类,缓冲,形成渗透压,参与免疫,参与凝血和抗凝血功能。
人体内血液的总量称为血量,是血浆量和血细胞的总和,但除红细胞外,其它血细胞数量很少,常忽略不计。每个人体内的血液量,是根据各人的体重来决定的。正常成人的血液总量,男子约占体重的8%,女子约占体重的7.5%左右。人体的血液总量不但在性别之间有差异,即使同一个人,在不同情况下也会有一定的改变。身体健壮的人比瘦弱的略多,运动员的血量较一般人多,妊娠期妇女血量增加较多。不过,在正常情况下,人的血量是相对恒定的,一般的增减不超过10%。
安全的血液指的是这样的血液,它不含有任何病毒、寄生虫、药物、酒精、化学物质或其他能给受血者带来损害、危险或疾病的外来物质。献血者必须身体健康,没有也未曾得过任何严重的疾病。受血者不应因受血而受到损害,献血者也不应因献血而招致风险。
血液的颜色是有差别的,血液的红色的来自红细胞内的血红蛋白,血红蛋白含氧量多时呈鲜红色(动脉血),含氧量少的呈暗红色(静脉血)。通常献血抽的是静脉血,所以外观看上去呈暗红色。若血含较多的是高铁血红蛋白或其他血红蛋白衍生物,则呈紫黑色。血浆(或血清)因含少量胆红素,看上去呈透明淡黄色;若含乳糜微粒,则呈乳白浑浊;若发生溶血,则呈红色血浆。
 血液细胞
血液细胞
血液由血浆和血细胞组成。
(一)血浆
血浆相当于结缔组织的细胞间质,其中血清为浅黄色半透明液体,血浆中除含有大量水分以外,还有无机盐、纤维蛋白原、白蛋白、球蛋白、酶、激素、各种营养物质、代谢产物等。这些物质无一定的形态,但具有重要的生理功能。
1L血浆中含有900~910g水(90%~91%)。65~85g蛋白质(6.5%~8.5% )和20g低分子物质(2%).低分子物质中有多种电解质和小分子有机化合物,如代谢产物和其他某些激素等。血浆中电解质含量与组织液基本相同。
(二)血细胞
在机体的生命过程中,血细胞不断地新陈代谢。红细胞的平均寿命约120天,颗粒白细胞和血小板的生存期限一般不超过10天。淋巴细胞的生存期长短不等,从几个小时直到几年。
血细胞及血小板的产生来自造血器官,红血细胞、有粒白血细胞及血小板由红骨髓产生,无粒白血细胞则由淋巴结和脾脏产生。
血细胞分为三类:红细胞、白细胞、血小板。
成人大约有5公升血液。以体积计,血细胞约占血液的45%。每公升血液有:
心脏节律性的搏动推动血液在心血管系统中按一定方向循环往复地流动。血液循环是英国哈维根据大量的实验、观察和逻辑推理于1628年提出的科学概念。然而限于当时的条件,他并不完全了解血液是如何由动脉流向静脉的。1661年意大利马尔庇基在显微镜下发现了动、静脉之间的毛细血管,从而完全证明了哈维的正确推断。动物在进化过程中,血液循环的形式是多样的。循环系统的组成有开放式和封闭式;循环的途径有单循环和双循环。人类血液循环是封闭式的,由体循环和肺循环两条途径构成的双循环。血液由左心室射出经主动脉及其各级分支流到全身的毛细血管,在此与组织液进行物质交换,供给组织细胞氧和营养物质,运走二氧化碳和代谢产物,动脉血变为静脉血;再经各级静脉汇合成上、下腔静脉流回右心房,这一循环为体循环。血液由右心室射出经肺动脉流到肺毛细血管,在此与肺泡气进行气体交换,吸收氧并排出二氧化碳,静脉血变为动脉血;然后经肺静脉流回左心房,这一循环为肺循环。
血型(blood%20groups;blood%20types)是以血液抗原形式表现出来的一种遗传性状。狭义地讲,血型专指红细胞抗原在个体间的差异;%20但现已知道除红细胞外,在白细胞、血小板乃至某些血浆蛋白,个体之间也存在着抗原差异。%20因此,广义的血型应包括血液各成分的抗原在个体间出现的差异。通常人们对血型的了解往往仅局限于ABO血型以及输血问题等方面,实际上,血型在人类学、遗传学、法医学、临床医学等学科都有广泛的实用价值,因此具有着重要的理论和实践意义,同时,动物血型的发现也为血型研究提供了新的问题和研究方向。
ABO血型
ABO血型可分为A、B、AB和O型等4种血型。红细胞含A抗原和H抗原的叫做A型,A型的人血清中含有抗B抗体;红细胞含B抗原和H抗原的叫做B型,B型的人血清中含有抗A抗体;红细胞含A抗原、B抗原和H抗原,叫做AB型,这种血型的人血清中没有抗A抗体和抗B抗体;红细胞只有H抗原,叫做O型,O型的人血清中含有抗A抗体和抗B抗体。另外,输血时以输同型血为原则。在必要时,可以少量输入O型血(O型血为万能输血者,AB型血为万能受血者)。
ABO血型物质除存在于红细胞膜上外,还出现于唾液、胃液、精液等分泌液中。中国60%汉族人唾液中有ABO血型物质。血型物质的化学本质是指构成血型抗原的糖蛋白或糖脂,而血型的特异性主要取决于血型抗原糖链的组成(即血型抗原的决定簇在糖链上)。A、B、H3种血型抗原化学结构的差异,仅在于糖链末端的1个单糖。A抗原糖链末端为N-乙酰半乳糖,而B抗原糖链末端为半乳糖,H抗原和A、B抗原相比则糖链末端少1个半乳糖或N-乙酰半乳糖。1981年已有人用绿咖啡豆酶(半乳糖苷酶)作用于B型红细胞,切去B抗原上的半乳糖,从而使B型转变成O型获得成功。
E.von邓格恩及L.希尔斯费尔德于1911年发现A血型的亚型。他们看到不同A型人的红细胞与抗A血清发生凝集反应的强度不一,在反应弱的A型人血清中还有一种抗体能与反应强的A型红细胞发生凝集反应。据此认为在A型中存在亚型;即A1及A2亚型。A1.型红细胞与抗A血清(来自B或O型人)反应强,而A2型红细胞与抗A血清反应弱。而且在部分A2型人的血清中,除存在的抗B外,还有不规则的抗A1。在B型人血清中有两种抗体:抗A及抗A1。抗A能与A1及A2细胞发生反应;抗A1只与A1细胞发生反应。A1型红细胞上有A及A1两种抗原。A2细胞上只有A抗原。AB型也可分为A1B及A2B等亚型。此外还有一些其他亚型。
MN血型
红细胞膜上另一类血型抗原叫MN抗原,即红细胞膜上的血型糖蛋白A。它在SDS凝胶电泳谱上显示两条区带,即PAS-1和PAS-2,血型糖蛋白A是两者的二聚物。已知血型糖蛋白A由131个氨基酸组成,其一级结构已测定(图2)。血型糖蛋白A的肽链呈三节式结构,中间第73~92号氨基酸为疏水性肽链,可横穿膜脂层;N端肽链位于膜外侧,与血型活性有关,在这段肽链上分布有15条O-糖苷键型糖链和1条N-糖苷键型糖链,糖链中唾液酸占红细胞膜上全部唾液酸的一半以上;C端肽链位于膜内侧,含较多酸性氨基酸。
MN抗原由M抗原和N抗原两部分组成,如果用神经氨酸酶将M抗原切去1个唾液酸(N-乙酰神经氨酸),则为N抗原,如再切去一个唾液酸则抗原性完全失去。MN抗原的抗原性还和肽链上的氨基有关,若将氨基用乙酰基保护后即失去抗原性。
白细胞血型——HLA
HLA是人类白细胞抗原中最重要的一类。与红细胞血型相比,人们对白细胞抗原的了解较晚,人体第一个白细胞抗原Mac是1958年法国科学家J.多塞发现的。HLA是人体白细胞抗原的英文缩写,已发现HLA抗原有144种以上,这些抗原分为A、B、C、D、DR、DQ和DP7个系列,而且HLA在其他细胞表面上也存在。
HLA抗原是一种糖蛋白(含糖为9%),其分子结构与免疫球蛋白极相似(图3)。HLA分子由4条肽链组成(含2条轻链和2条重链),重链上连接2条糖链。HLA分子部分镶嵌在细胞膜的双脂层中,其插入膜的部分相当于免疫球蛋白IgG的Fc区段,轻链为β-微球蛋白。由于分子结构上的相似,故HLA与有保卫功能的免疫防御系统密切相关。
此外,HLA和红细胞血型一样都受遗传规律的控制。决定HLA型的基因在第6对染色体上。每个人分别可从父母获得一套染色体,所以一个人可以同时查出A、B、C、D和DR5个系列中的5~10种白细胞型,因此表现出来的各种白细胞型有上亿种之多。在无血缘关系的人间找出HLA相同的两个是很困难的。但同胞兄弟姊妹之间总是有1/4机会HLA完全相同或完全不同。因此法医鉴定亲缘关系时,HLA测定是最有力的工具。
输血
应以输同型血为原则,只有在没有同型血且十分紧急的情况中,才能输入异型血。在这种情况下,O型血可以少量(不大于200ml)输给各类血型,AB型血的病人也可以接受少于200ml的任何血型的血液。
每年6月14日“世界献血者日”
血细胞分为三类:红细胞、白细胞、血小板。
红细胞
 血液
血液
红细胞有一定的弹性和可塑性,细胞通过毛细血管时可改变形状。红细胞正常形态的保持需ATP供给能量,由于红细胞缺乏线粒体,ATP只由无氧糖酵解产生;一旦缺乏ATP供能,则导致细胞膜结构改变,细胞的形态也随之由圆盘状变为棘球状。这种形态改变一般是可逆的。可随着ATP的供能状态的改善而恢复。
成熟红细胞无细胞核,也无细胞器,胞质内充满血红蛋白(hemoglobin,Hb)。血红蛋白是含铁的蛋白质,约占红细胞重量的33%。它具有结合与运输O2和CO2的功能,当血液流经肺时,肺内的O2分压高(102mmHg),CO2分压低(40mmHg),血红蛋白(氧分压40mmHg,二氧化碳分压46mmHg)即放出CO2而与O2结合;当血液流经其它器官的组织时,由于该处的CO2分压高(46mmHg)而O2分压低(40mmHg),于是红细胞即放出O2并结合CO2。由于血红蛋白具有这种性质,所以红细胞能供给全身组织和细胞所需的O2,带走所产生的部分CO2。
 血液中的红细胞
血液中的红细胞
红细胞的渗透压与血浆相等,使出入红细胞的水分维持平衡。当血浆渗透压降低时,过量水分进入细胞,细胞膨胀成球形,甚至破裂,血红蛋白逸出,称为溶血(hemolysis);溶血后残留的红细胞膜囊称为血影(ghost)。反之,若血浆的渗透压升高,可使红细胞内的水分析出过多,致使红细胞皱缩。凡能损害红细胞的因素,如脂溶剂、蛇毒、溶血性细菌等均能引起溶血。
红细胞的细胞膜,除具有一般细胞膜的共性外,还有其特殊性,例如红细胞膜上有ABO血型抗原。
外周血中除大量成熟红细胞以外,还有少量未完全成熟的红细胞,称为网织红细胞(reticulocyte)在成人约为红细胞总数的0.5%~1.5%,新生儿较多,可达3%~6%。网织红细胞的直径略大于成熟红细胞,在常规染色的血涂片中不能与成熟红细胞区分。用煌焦蓝作体外活体染色,可见网织红细胞的胞质内有染成蓝色的细网或颗粒,它是细胞内残留的核糖体。核糖体的存在,表明网织红细胞仍有一些合成血红蛋白的功能。红细胞完全成熟时,核糖体消失,血红蛋白的含量即不再增加。贫血病人如果造血功能良好,其血液中网织红细胞的百分比值增高。因此,网织红细胞的计数有一定临床意义,它是贫血等某些血液病的诊断、疗效判断和估计预指标之一。
红细胞的平均寿命约120天。衰老的红细胞虽无形态上的特殊,但其机能活动和理化性质都有变化,如酶活性降低,血红蛋白变性,细胞膜脆性增大,以及表面电荷改变等,因而细胞与氧结合的能力降低且容易破碎。衰老的红细胞多在脾、骨髓和肝等处被巨噬细胞吞噬,同时由红骨髓生成和释放同等数量红细胞进入外周血液,维持红细胞数的相对恒定。
成熟的红细胞没有细胞核。
白细胞
 血液的组成
血液的组成
光镜下,根据白细胞胞质有无特殊颗粒,可将其分为有粒白细胞和无粒白细胞两类。有粒白细胞又根据颗粒的嗜色性,分为中性粒细胞、嗜酸性粒细胞和嗜碱性粒细胞。无粒白细胞有单核细胞和淋巴细胞两种。
中性粒细胞:
中性粒细胞(neutrophilic granulocyte,neutrophil)占白细胞总数的50%-70%,是白细胞中数量最多的一种。细胞呈球形,直径10-12μm,核染色质呈团块状。核的形态多样,有的呈腊肠状,称杆状核;有的呈分叶状,叶间有细丝相连,称分叶核。细胞核一般为2~5叶,正常人以2~3叶者居多。在某些疾病情况下,核1~2叶的细胞百分率增多,称为核左移;核4~5叶的细胞增多,称为核右移。一般说核分叶越多,表明细胞越近衰老,但这不是绝对的,在有些疾病情况下,新生的中性粒细胞也可出现细胞核为5叶或更多叶的。杆状核粒细胞则较幼稚,约占粒细胞总数的5%~10%,在机体受细菌严重感染时,其比例显著增高。
中性粒细胞的胞质染成粉红色,含有许多细小的淡紫色及淡红色颗粒,颗粒可分为嗜天青颗粒和特殊颗粒两种。嗜天青颗粒较少,呈紫色,约占颗粒总数的20%,光镜下着色略深,体积较大;电镜下呈圆形或椭圆形,直径0.6~0.7μm,电子密度较高,它是一种溶酶体,含有酸性磷酸酶和过氧化物酶等,能消化分解吞噬的异物。特殊颗粒数量多,淡红色,约占颗粒总数的80%,颗粒较小,直径0.3~0.4μm,呈哑铃形或椭圆形,内含碱性磷酸酶、吞噬素、溶菌酶等。吞噬素具有杀菌作用,溶菌酶能溶解细菌表面的糖蛋白。
中性粒细胞具有活跃的变形运动和吞噬功能。当机体某一部位受到细菌侵犯时,中性粒细胞对细菌产物及受感染组织释放的某些化学物质具有趋化性,能以变形运动穿出毛细血管,聚集到细菌侵犯部位,大量吞噬细菌,形成吞噬小体。吞噬小体先后与特殊颗粒及溶酶体融合,细菌即被各种水解酶、氧化酶、溶菌酶及其它具有杀菌作用的蛋白质、多肽等成分杀死并分解消化。由此可见,中性粒细胞在体内起着重要的防御作用。中性粒细胞吞噬细胞后,自身也常坏死,成为脓细胞。中性粒细胞在血液中停留约6~7小时,在组织中存活约1~3天。
嗜酸性粒细胞:
 临床用血
临床用血
嗜酸性粒细胞也能作变形运动,并具有趋化性。它能吞噬抗原抗体复合物,释放组胺酶灭活组胺,从而减弱过敏反应。嗜酸性粒细胞还能借助抗体与某些寄生虫表面结合,释放颗粒内物质,杀灭寄生虫。故而嗜酸性粒细胞具有抗过敏和抗寄生虫作用。在过敏性疾病或寄生虫病时,血液中嗜酸性粒细胞增多。它在血液中一般仅停留数小时,在组织中可存活8~12天。
嗜碱性粒细胞:
嗜碱性粒细胞(basoophilic granulocyte,basophil)数量最少,占白细胞总数的0~15。细胞呈球形,直径10-12μm。胞核分叶或呈S形或不规则形,着色较浅。胞质内含有嗜碱性颗粒,大小不等,分布不均,染成蓝紫色,可覆盖在核上。颗粒具有异染性,甲苯胺蓝染色呈紫红色。电镜下,嗜碱性颗粒内充满细小微粒,呈均匀状或螺纹状分布。颗粒内含有肝素和组胺,可被快速释放;而白三烯则存在于细胞基质内,它的释放较前者缓慢。肝素具有抗凝血作用,组胺和白三烯参与过敏反应。嗜碱性粒细胞在组织中可存活12-15天。
嗜碱性粒细胞与肥大细胞,在分布、胞核的形态,以及颗粒的大小与结构上,均有所不同。但两种细胞都含有肝素、组胺和白三烯等成分,故嗜碱性粒细胞的功能与肥大细胞相似,但两者的关系尚待研究。
单核细胞:
单核细胞(monocyte)占白细胞总数的3%~8%。它是白细胞中体积最大的细胞。直径14~20μm,呈圆形或椭圆形。胞核形态多样,呈卵圆形、肾形、马蹄形或不规则形等。核常偏位,染色质颗粒细而松散,故着色较浅。胞质较多,呈弱嗜碱性,含有许多细小的嗜天青颗粒,使胞质染成深浅不匀的灰蓝色。颗粒内含有过氧化物酶、酸性磷酸酶、非特异性酯酶和溶菌酶,这些酶不仅与单核细胞的功能有关,而且可作为与淋巴细胞的鉴别点。电镜下,细胞表面有皱褶和微绒毛,胞质内有许多吞噬泡、线粒体和粗面内质网,颗粒具溶酶体样结构。
 血液透析图
血液透析图
淋巴细胞:
淋巴细胞(lymphocyte)占白细胞总数的20%~30%,圆形或椭圆形,大小不等。直径6~8μm的为小淋巴细胞,9~12μm的为中淋巴细胞, 13~20μm的为大淋巴细胞。小淋巴细胞数量最多,细胞核圆形,一侧常有小凹陷,染色质致密呈块状,着色深,核占细胞的大部,胞质很少,在核周成一窄缘,嗜碱性,染成蔚蓝色,含少量嗜天青颗粒。中淋巴细胞和大淋巴细胞的核椭圆形,染色质较疏松,故着色较浅,胞质较多,胞质内也可见少量嗜天青颗粒。少数大、中淋巴细胞的核呈肾形,胞质内含有较多的大嗜天青颗粒,称为大颗粒淋巴细胞、电镜下,淋巴细胞的胞质内主要是大量的游离核糖体,其他细胞器均不发达。
以往曾认为,大、中、小淋巴细胞的分化程度不同,小淋巴细胞为终末细胞。但如今普遍认为,多数小淋巴细胞并非终末细胞。它在抗原刺激下可转变为幼稚的淋巴细胞,进而增殖分化。而且淋巴细胞也并非单一群体,根据它们的发生部位、表面特征、寿命长短和免疫功能的不同,至少可分为T细胞、B细胞、杀伤(K)细胞和自然杀伤(NK)细胞等四类。
血液中的T细胞约占淋巴细胞总数的75%,它参与细胞免疫,如排斥异移体移植物、抗肿瘤等,并具有免疫调节功能。B细胞约占血中淋巴细胞总数的10%~15%。B细胞受抗原刺激后增殖分化为浆细胞,产生抗体,参与体液免疫(详见免疫系统)。
血小板
血小板(platelet)是哺乳动物血液中的有形成分之一。它有质膜,没有细胞核结构,一般呈圆形,体积小于红细胞和白细胞。 血小板在长期内被看作是血液中的无功能的细胞碎片。直到1882年意大利医师J.B.比佐泽罗发现它们在血管损伤后的止血过程中起着重要作用,才首次提出血小板的命名。
血小板具有特定的形态结构和生化组成,在正常血液中有较恒定的数量(如人的血小板数为每立方毫米10~30万),在止血、伤口愈合、炎症反应、血栓形成及器官移植排斥等生理和病理过程中有重要作用。
血小板只存在于哺乳动物血液中。低等脊椎动物圆口纲有纺锤细胞起凝血作用,鱼纲开始有特定的血栓细胞。两栖、爬行和鸟纲动物血液中都有血栓细胞,血栓细胞是有细胞核的梭形成椭圆形细胞,功能与血小板相似。无脊椎动物没有专一的血栓细胞,如软体动物的变形细胞兼有防御和创伤治愈作用。甲壳动物只有一种血细胞,兼有凝血作用。
血小板为圆盘形,直径1~4微米到7~8微米不等,且个体差异很大(5~12μm3)。血小板因能运动和变形,故用一般方法观察时表现为多形态。血小板结构复杂,简言之,由外向内为3层结构,即由外膜、单元膜及膜下微丝结构组成的外围为第1层;第2层为凝胶层,电镜下见到与周围平行的微丝及微管构造;第3层为微器官层,有线粒体、致密小体、残核等结构。
血细胞形态、数量、比例和血红蛋白含量的测定称为血像。患病时,血像常有显著变化,故检查血像对了解机体状况和诊断疾病十分重要。
1、为身体各处输送氧气,主要由红细胞负责。
2、输送营养,例如葡萄糖、氨基酸、脂肪酸等。
3、带走废物,例如二氧化碳、尿酸、乳酸等。
4、提供免疫功能,由白细胞及抗体负责。
5、信息功能,例如激素及组织损坏讯号。
6、调节体内的酸碱值。
7、调节体温。
8、液压功能。
血液成份或循环出现问题时,可引致下游组织不能有效运作。“局部缺血”指身体某些部位得不到足够血液流通。心脏的泵血功能使血液流经肺部及其它器官,重力及肌肉活动亦帮助血液流回心脏再循环运行。在哺乳类动物中,血液与淋巴液形成一种平衡,后者由血液经过毛细血管的超滤作用而形成,从胸导管回到血液。
运输
运输是血液的基本功能,自肺吸入的氧气以及由消化道吸收的营养物质,都依靠血液运输才能到达全身各组织。同时组织代谢产生的二氧化碳与其他废物也赖血液运输到肺、肾等处排泄,从而保证身体正常代谢的进行。血液的运输功能主要是靠红细胞来完成的。贫血时,红细胞的数量减少或质量下降,从而不同程度地影响了血液这一运输功能,出现一系列的病理变化。
体液调节
激素分泌直接进入血液,依靠血液输送到达相应的靶器官,使其发挥一定的生理作用。可见,血液是体液性调节的联系媒介。此外,如酶、维生素等物质也是依靠血液传递才能发挥对代谢的调节作用的。
内环境稳态
由于血液不断循环及其与各部分体液之间广泛沟通,故对体内水和电解质的平衡、酸碱度平衡以及体温的恒定等都起决定性的作用。
防御功能
机体具有防御或消除伤害性刺激的能力,涉及多方面,血液体现其中免疫和止血等功能。例如,血液中的白细胞能吞噬并分解外来的微生物和体内衰老、死亡的组织细胞,有的则为免疫细胞,血浆中的抗体如抗毒素、溶菌素等均能防御或消灭入侵机体的细菌和毒素。上述防御功能也即指血液的免疫防御功能,主要靠白细胞实现。此外,血液凝固对血管损伤起防御作用。
调节体温
血液的组成部分最多的是水分,约占90%。而水又有调节体温的作用。
血液里的水是这样调节体温的:由于人体含有大量的水,代谢过程中所产生的热能为水所吸收,使体温不至于显著升高;其实是水的蒸发数值大,每毫升水的蒸发热约为579.5千卡,(37")故人体只要蒸发少量的水即可散发大量的热,以维持人体一定的体温,如外界环境温度高,体热可随水分经皮肤蒸发散热,以维持人体体温的恒定。
一般健康人如果一次失血不超过总血量的10%,对身体影响不太大。当一次失血超过总血量的 20% 时,则对健康有严重影响;超过总血量的30%时就会危及生命。因为血液在心血管内循环流动,遍及全身。它保持着整个身体与外界环境间的联系,也维持着各器官组织间的相互联系。具体说来,血液具有如下重要的生理功能 :
运输物质
从消化道吸收的各种营养物质、肺部吸入的氧,都要通过血液运输到全身各器官组织,供其利用;全身各种组织在代谢过程中所产生的代谢产物,如尿素、肌酐及二氧化碳等也需要通过血液运送到排泄器官——肾、肺、皮肤及肠道等而排出体外。进入体内的药物也要通过血液分布到体内不同部位。
维持组织的兴奋性
维持机体各种组织正常兴奋性需要有合适而恒定的内环境,如温度、酸碱度(pH)、渗透压及各种离子浓度等,血液对维持内环境的恒定起着十分重要的作用,例如血液中的缓冲系统(如碳酸氢钠和碳酸、血浆蛋白、红细胞中的血红蛋白等)具有缓冲酸性或碱性物质的作用,使血液的pH值维持在7.35~7.45。血浆中各种无机离子的含量及其比例对维持神经、肌肉的正常兴奋性,尤其是心肌的兴奋性至关重要。
调节机能
调节内分泌腺所分泌的激素,组织的特殊产物及一般代谢产物,如甲状腺素、肾上腺素、肾素、组胺、二氧化碳和乳酸等都要通过血液循环而分布到身体各器官组织,从而对各器官系统的机能活动进行调节。
防御作用
血液中的白细胞有吞噬细菌和异物的作用,血浆中的各种抗体有免疫作用,从而使机体能防御外界有害因素的入侵而保持身体的健康。
由于血液具有上述重要的生理机能,一旦血液的总量过分减少,或其组成成分发生异常变化,都可引起严重的后果。
输血是临床上抢救危重病人和治疗某些疾病的一项重要措施。那么,输用的血液来自何处。尽管如今有了多种血液代用品,但志愿献血者提供的血液,仍然是一个重要来源。也许有人会问:献血会影响健康吗。
血液在心血管系统中不断地循环流动,完成各种运输功能。人体的血液总量是相对恒定的,这对于人体正常机能的维持很有必要。但血量在一定范围内的变动是经常发生的,这属于正常的生理现象。健康的成年人,全身血量占体重的7%~8%,例如,体重60公斤的人,血量为4200~4800毫升。临床研究表明,一个健康的成年人,一次失血.如果不超过血液总量的10%,通过机体的调节,血压仍可维持正常,没有明显的心血管机能障碍和临床症状,对健康没有明显的影响,而且失去的血量也能较快得到恢复。失血后,首先是贮血器官(肺、脾、肝等)中的血管收缩,放出一部分血液补充循环血量;同时.一部分组织液通过毛细血管壁进入血管,可使血量在1~2小时内复原;损失的血浆蛋白,由于肝脏加速合成,可在1~2天内完全恢复;损失的红细胞由骨髓造血组织加速生成来补充,红细胞数量可在1个月左右复原。因此,正常成年人一次献血200~300毫升,不会影响健康。献血前1天睡眠要充足,献血后应休息1天,还应适当地增加一些营养。如果身体不适(如患感冒、腹泻等)以及妇女月经期间,就暂缓献血。
制造及降解
血细胞在骨髓产生,过程称为“血细胞生成”。蛋白质构成部分,包括凝血因子,主要由肝脏产生,而激素由内分泌腺产生,至于水状成份则由丘脑下部调节肾脏去维持,肠道也有份间接参与。
血细胞在脾脏及肝枯否细胞降解,肝也有移除一些蛋白质、脂肪及氨基酸。肾脏把身体的废物带进尿液。正常的红细胞在血浆中约有120天寿命。
输送氧气
一个在正常气压环境中呼吸的健康人类,他的动脉血液中的氧约有98.5%与血红素产生化学结合,只有1.5%是溶于其它血液成份中。血红素也是哺乳类及许多其它物种的主要氧输送者。
除了肺动脉、脐动脉及两者的对应静脉外,带氧血液从心脏经过动脉、小动脉及毛细血管到达身体各处,然后脱氧血液经小静脉及静脉流回心脏。
在正常情形下,人在休息时,离开肺部的血液中的血红素约有98—99%被氧饱和。一个健康成人在休息时,回到肺部的“脱氧”血液仍然约有75%氧饱和。持续运动增加氧的消耗,减少静脉血液的氧饱和,在一个受过训练的运动员身上可降至少于15%,即使呼吸率及血流增加,动脉血液的氧饱和在这些情形下可降至95%或更低。对于一个正在休息(例如在手术期间被麻醉)的人来说,这样低的静脉氧饱和被视为危险Template:Todo:此段文字容易引起误解,请继续修缮。
由于母体供应胎盘的血液的氧分压只有成人肺部的20%,胎儿制造了一种具有更强氧亲和力的血红素(血红素F),确保可以从血液中尽可能地取得足够的氧。
除了氧外,一些物质也可与血红素结合,有时候可以造成身体的永久性损害。一氧化碳是其中之一,它与血红素结合成不可还原的碳氧血红素,从而降低血液的载氧量,严重时可引致身体缺氧,造成器官的永久性损害甚至死亡。
昆虫的血(更恰当的称呼是血淋巴)不参与氧的输送。昆虫身上的气孔容许空气中的氧直接扩散到身体组织。
伤口流血
血管闭塞,可引致局部缺血,令组织坏死。
血友病
白血病
贫血
地中海贫血
红细胞增多症
正铁血红蛋白血症
经血液传播的传染病
败血症
血液的生成很有趣,就像田径场上的接力跑,参与者有胚胎的卵黄囊、肝、脾、肾、淋巴结、骨髓等。造血始于人胚的第3周,此阶段还没有什么器官形成,一个叫卵黄囊的胚胎组织担起造血的第一责任。
人胚第6周,人体器官形成,肝脏接着造血。人胚第3个月,脾是主要的造血器官。人胚第4个月后,骨髓开始造血,这是人体最重要的造血组织。出生后,肝、脾造血停止,骨髓负起造血的全部责任。
血细胞包括红细胞、白细胞、血小板等,它们各司其职,但都来自同一种细胞——多功能干细胞。由这种细胞增殖、分化和成熟,才变为在血管里流动的各种终末血细胞。
人体血液抹片
人体血液抹片
每个人体内的血液,都是自己体内产生的,不是由母体血液流入胎儿血管先天带来的。
胎儿早期发育时,在其胚胎体内部,就逐步产生了自己的造血中心。当胚胎发育到第三周时,卵黄囊壁上的血岛就是第一个造血的中心,这个中心的造血期到第九周为止。胚胎发育到第六周时,肝脏开始造血,9-24周的胎儿,肝脏是主要的造血场所。肝脏造血以红细胞为主,同时也少量生成粒细胞和巨核细胞,但不生成淋巴细胞。在这期间,脾、肾、胸腺和淋巴结等处也参与造血。脾脏产生于胚胎第三个月,开始以生成红细胞为优势,以后也生成一定数量的粒细胞、淋巴细胞和单核细胞。胸腺为人体周围淋巴组织提供前T细胞,这就是为身体生成具有免疫功能的T淋巴细胞的来源。淋巴结参与早期生成红细胞,但到胚胎发育进入第四个月后,就成为终身造淋巴细胞和浆细胞的器官。当胚胎发育进入第四个月以后,骨髓开始造血,到第五个月以后,肝、脾造血功能逐步减退,骨髓造血功能迅速增加,成为红细胞、粒细胞和巨核细胞的主要生成器官,同时也产生淋巴细胞和单核细胞。 胎儿出生以后,肝脏造血功能很快停止,但脾脏仍是终身造淋巴细胞的器官,而骨髓则是人体最重要的造血器官。在正常情况下它不仅生成红细胞、粒细胞和血小板,同时也生成淋巴细胞和单核细胞。骨髓每秒钟可造出1700万个血细胞。
人体血液中所有不同的血细胞,都是来自于肝脏、骨髓和胸腺里的始祖细胞——多能干细胞及由此移行的定向干细胞。这就是人体血液产生的基本道理。
血液本身是一种高营养的物质,因此造血也必须有很广的营养原料。造血所需的主要原料有蛋白质、碳水化合物、铁、铜、叶酸、维生素C、维生素B12以及多种微量元素和激素等物质。
蛋白质是生命存在的重要基础,血液中最主要的物质就是各种蛋白质,尤其是红细胞。如果蛋白质供量不足,造血器官就无法生产出优质的血液,就会出现贫血而直接影响身体的健康。成人每天需要蛋白质约75克。蛋白质原料的食品,主要有鱼、肉、蛋类、奶类、豆类以及玉米、马铃薯、花生等。
铁是血红蛋白中的主要成分。血红蛋白携带氧气和二氧化碳的功能是通过血红蛋白中的铁的结合作用来完成的。如果铁量不够,就会出现缺铁性贫血。成年人每天需要铁量为12毫克。含铁较多的食品主要有海带、黑木耳、菠菜,其次是动物的肝脏、血、肉、蛋黄,豆类、稻米中也有较多的铁含量。
叶酸对于蛋白质的生物合成有重要影响。如果供量不足,就会出现巨红细胞贫血,这也叫叶酸缺乏病。成人每天需要量为200微克。含这种物质较多的食品有肉类、肝脏、豆类、蛋类、水果及绿叶蔬菜等。
维生素B12、维生素C及其他多种微量元素和激素等,虽然在红细胞内含量不多,但对红细胞的成熟和铁的吸收等造血过程,都是不可缺少的物质。不同的食品,所含营养物质的种类和数量不尽相同,因此在膳食时应力求广泛多样。这样做可使机体在摄取营养过程中可以达到充分的互补。为了更好地摄取造血需要的营养原料,既不可暴饮暴食,又不要偏食。
造血的物质指的是制造红细胞的物质,主要有蛋白质、铁、维生素B12、B6、叶酸等。蛋白质来源自肉类及豆类;铁来源自蛋黄、牛肉、肝、肾、豆类、叶绿素、海带及波菜等,另一个重要来源为铁锅所游离出来的少量铁;B12及B6来源较多的是肉、肝、肾、蔬菜等;叶酸的主要来源为蔬菜、酵母及动物内肝。
在诸多造血物质中,铁是主要的物质,也是非常容易流失的物质,人体内铁平均量约为3-4.5g,男性全身铁量约为500mg/kg,女性为35 mg/kg,铁在十二指肠及空肠上段被吸收进入血液,并与其他物质结合组成10类以上有生理功能的化合物,其中最重要的是铁与卟啉环结合成血红素,血红素是红蛋白的主要物质,而血红蛋白又是红细胞的主要物质。据测定,红细胞中的96%是血红蛋白。维生素B12和叶酸是合成DNA的主要辅酶,这两种物质如果不足,将会引起幼红细胞的发育障碍。
血液的温度为37摄氏度,密度为1.050—1.060×10^3kg/m^3, 红细胞的密度为1.090×10^3kg/m^3, 血浆的密度为1.025—1.030×10^3kg/m^3。 血液也是有粘稠度的,即血液在血管内流动的粘滞力,主要取决于红细胞的数量和血浆蛋白的浓度。全血的相对粘稠度为纯水的4—5倍;血浆为1.6—2.4倍;血清粘稠度为1.5倍。血液的pH值为7.35—7.45,静脉血因含较多的二氧化碳,pH较低,接近7.35,而动脉血则接近7.45,常人血浆在37摄氏度时渗透压为7.6大气压。
血液的颜色是有差别的,血液的红色的来自红细胞内的血红蛋白,血红蛋白含氧量多时呈鲜红色(动脉血),含氧量少的呈暗红色(静脉血)。通常献血抽的是静脉血,所以外观看上去呈暗红色。若血含较多的是高铁血红蛋白或其他血红蛋白衍生物,则呈紫黑色。血浆(或血清)因含少量胆红素,看上去呈透明淡黄色;若含乳糜微粒,则呈乳白浑浊;若发生溶血,则呈红色血浆。
艾滋病
1.不吸毒。有毒瘾者要戒毒,戒毒前不要共用注射器和针头注射毒品。
2.不去消毒得不到保证的医院、诊所打针、拔牙或做手术。
3.儿童打预防针必须一人一针一管。
4.不到不消毒的理发摊、店和美容院去理发、美容。
5.不用不消毒的针穿耳、文身。
6.修脚、治鸡眼的刀一定要消毒。
7.刮脸刀、电动剃须刀、牙刷必须自备,不可借用。
8.救护流血伤员,要防止血液沾在自己皮肤粘膜上。
9.体育活动引起的外伤流血也有传染危险。
1、本站所有文本、信息、视频文件等,仅代表本站观点或作者本人观点,请网友谨慎参考使用。
2、本站信息均为作者提供和网友推荐收集整理而来,仅供学习和研究使用。
3、对任何由于使用本站内容而引起的诉讼、纠纷,本站不承担任何责任。
4、如有侵犯你版权的,请来信(邮箱:baike52199@gmail.com)指出,核实后,本站将立即删除。






























